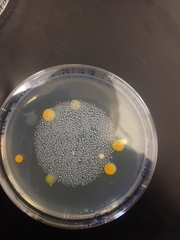
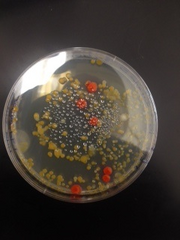
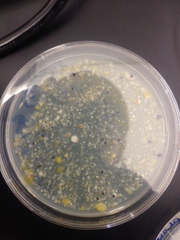

Uploads by Erin McDonough
From OpenWetWare
Jump to navigationJump to search
This special page shows all uploaded files.
| Date | Name | Thumbnail | Size | Description |
|---|---|---|---|---|
| 15:50, 19 March 2015 | ZFtest.png (file) |  |
256 KB | |
| 15:50, 19 March 2015 | ZFcontrol.png (file) |  |
274 KB | |
| 13:34, 19 February 2015 | Springtails.png (file) |  |
236 KB | |
| 04:48, 19 February 2015 | FoodWeb-Erin.png (file) |  |
52 KB | |
| 06:43, 12 February 2015 | Rose bush.png (file) |  |
196 KB | |
| 06:43, 12 February 2015 | Thorin.png (file) |  |
179 KB | |
| 06:42, 12 February 2015 | Leaves.png (file) |  |
94 KB | |
| 16:07, 5 February 2015 | Tet-10-9.png (file) |  |
114 KB | |
| 16:07, 5 February 2015 | Tet-10-7.png (file) |  |
101 KB | |
| 16:07, 5 February 2015 | Tet-10-5.png (file) | |
105 KB | |
| 16:06, 5 February 2015 | Tet-10-3.png (file) | |
92 KB | |
| 16:06, 5 February 2015 | Nut-10-9.png (file) |  |
101 KB | |
| 16:06, 5 February 2015 | Nut-10-7.png (file) |  |
90 KB | |
| 16:06, 5 February 2015 | Nut-10-5.png (file) |  |
99 KB | |
| 16:05, 5 February 2015 | Nut-10-3.png (file) | |
119 KB | |
| 15:57, 5 February 2015 | Tet-10-7.jpg (file) |  |
27 KB | |
| 15:57, 5 February 2015 | Tet-10-5.jpg (file) |  |
27 KB | |
| 15:56, 5 February 2015 | Tet-10-3.jpg (file) |  |
26 KB | |
| 15:56, 5 February 2015 | Nut-10-9.jpg (file) |  |
28 KB | |
| 15:56, 5 February 2015 | Nut-10-7.jpg (file) |  |
23 KB | |
| 15:56, 5 February 2015 | Nut-10-5.jpg (file) |  |
26 KB | |
| 15:56, 5 February 2015 | Nut-10-3.jpg (file) |  |
32 KB | |
| 16:37, 29 January 2015 | Protozoa-Erin .png (file) |  |
71 KB | |
| 04:48, 27 January 2015 | Transect-Erin.png (file) |  |
309 KB | |
| 04:40, 27 January 2015 | Transect-Erin.JPG (file) |  |
63 KB | |
| 04:32, 27 January 2015 | Transect.JPEG (file) |  |
63 KB | |
| 04:21, 27 January 2015 | Transect-Erin.JPEG (file) |  |
76 KB |